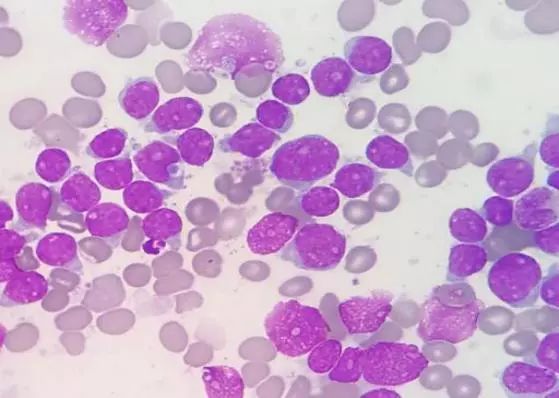
含硒代蛋氨酸的补剂(l硒代蛋氨酸是有机硒吗)-硒宝网

含硒代蛋氨酸的补剂(l硒代蛋氨酸是有机硒吗)
硒对动物和人免疫功能影响的研究始于 20 世纪 70 年代初 ,日趋受到人们的高度重视[ 123 ] 。已有的研究显示 ,硒是免疫系统调节的重要组分 ,主要参与调节 T 淋巴细胞、B 淋巴细胞、N K 细胞和中性粒细胞的功能[ 4 ] 。硒缺乏时 ,机体合成免疫球蛋白的功能下降 , T 淋巴细胞分化增殖能力下降[526 ] 。营养水平硒或一定范围的高于营养水平的硒摄入能增强疫苗的免疫效果 ,改善抗体生成 ,提高 B 淋巴细胞的活化增殖能力 ,增强 T 淋巴细胞功能 ,增加中性粒细胞数量 ,并能促使硒渗入脾、肝和淋巴结等免疫器官[7 ] 。但过量摄入硒 ,则会损伤细胞免疫和体液 免疫功能[829 ] 。
1 硒对免疫器官病理形态学的影响
硒缺乏家禽的胸腺、脾和法氏囊发育不良 ,均有局灶或弥漫性坏死 ,淋巴细胞明显减少[ 9211 ] 。胸腺淋巴细胞数量减少且呈退行性变 ,病变严重者见小静脉、毛细血管明显充血、血栓形成 ,多量巨噬细胞、假嗜伊红白细胞浸润 ,网状上皮细胞增生 ,小叶结构丧失。脾红髓淋巴细胞显著减少且呈退行性变 ,网状细胞增多 ;白髓萎缩 ,淋巴细胞显著减少甚至完全消失 ,红白髓界限消失。法氏囊发育受阻 ,淋巴滤泡皮质淋巴细胞显著减少 ;髓质扩大 ,散在残存的淋巴细胞及网状细胞 ,皮髓质界限消失。严重者淋巴滤泡缩小 ,网状细胞大量增生形成实心细胞团 ,原有淋巴组织结构消失。其周围见结缔组织增生和巨噬细胞浸润。盲肠扁桃体的弥散性淋巴组织和淋巴滤泡结构疏松 ,淋巴细胞减少 ,浸润有假嗜伊红白细胞。
有关硒中毒时禽类免疫器官病理组织学变化的研究较少。Earl 等[ 12 ] 以 DL2硒蛋氨酸为硒源添加至成年野鸭日粮中 ,当硒含量为 20 mg/ kg 时 ,21 只野鸭死亡 1 只 ,40 mg/ kg 组死亡 3 只 ,80 mg/ kg 组全部死亡。死于硒中毒野鸭的脾淋巴滤泡数量减少 ,直径减小 ,严重者甚至消失 ;滤泡生发中心淋巴细胞数量减少。对 1 只野鸭的胸腺进行组织学观察 ,发现胸腺组织重度萎缩 ,皮质区淋巴细胞数量显著减少。食道黏膜下的消化道相关淋巴组织体积减小 ,淋巴细胞数量减少 ,缺乏生发中心。张守发等[ 13 ]观察到硒中毒雉鸡的脾发生萎缩 ,镜下白髓萎缩 ,淋巴细胞减少 ,红细胞散在或聚集于脾髓内。邓桦等[14 ]报道 ,硒中毒鸵鸟的脾白髓中央动脉周围出现多量匀质红染的无结构物质 ,其间有大小不一的红染透明滴。
2 硒的抗炎反应对细胞因子的影响
硒通过 1 型和 4 型谷胱甘肽过氧化物酶清除机体内的过氧化物 ,保持细胞氧化还原状态平衡 ,而机体内的过氧化物介导活性白细胞三烯 (L TB4) 产生[15 ] 。白细胞三烯是一种趋化因子 ,诱导中性粒细胞进入炎症区[16 ] 。因此 ,硒通过清除活性氧物质来抑制炎症介质释放 ,从而可能具有抗炎效应[ 15 ] ?;芳友趺复呋ㄉ南┧嶙傲邢偎?。高水平超氧化物抑制此酶 ,而 GSH2Px 和硫氧还蛋白还原酶通过清除超氧化物而活化此酶。硒的抗炎机理还与硒酶抑制 52和 152脂肪氧化酶活性有关[15 ] 。
硒缺乏的又一重要影响是干扰前凝血物质血栓素与抗凝前列环素产生的平衡。这可以解释为什么低硒摄入的人群易患动脉粥样硬化症。有资料表明 ,补硒只能?;の闳肓康陀谌胀萍黾亮康娜嗣饣级鲋嘌不ⅰ6匀说难芯勘砻?, 血小板GSH2Px1 活性对硒缺乏敏感 ,这与硒缺乏时血小板凝集反应增强 ,血栓素 B2 和脂肪氧化酶衍生产物增多密切相关 ,而补硒可以增强 GSH2Px1 的活性 ,降低血小板过凝集反应[ 15 ] 。
前炎性细胞因子 ,如肿瘤坏死因子α( TNF2α)和 IL21 ,能诱导多种黏附分子在炎症过程中上调表 达。硒通过调节细胞因子影响黏附分子表达。硒耗竭细胞或来源于低硒个体的上皮细胞通常高表达黏附分子 ,补硒则减少黏附分子表达[17 ] 。体外试验显示 ,硒缺乏时 ,中性粒细胞更易黏附到内皮细胞 ,而这是重要的炎症早期过程[18 ] 。GSH2Px 可抑制黏附分子表达[ 19220 ] 。
不同种类的硒化合物对细胞因子的影响不同。例如 ,蛋氨酸硒与亚硒酸盐相比 ,对紫外线照射后产生细胞因子的过程有更好的?;ぷ饔?。用亚硒酸盐处理内皮细胞 ,培养液中的细胞因子增多[21 ] 。给BALB/ c 小鼠添加亚硒酸钠 ,能促进植物血凝素刺激的脾巨噬细胞分泌 IL21 和 TNF2α。这可能是由高剂量亚硒酸钠的前氧化效果所致的[17 ] 。
与硒缺乏状态相比 ,适量硒能促进淋巴细胞分泌某些淋巴因子 ,增强机体免疫功能。人外周淋巴 细胞在含硒 1 ×10 – 9 ~1 ×10 – 6 mol/ L 条件下培养后 ,其产生干扰素的能力提高。在小鼠淋巴细胞的体外培养中加硒 ,培养细胞分泌 IL22 的能力提高 ;体外培养加生理浓度的硒 ,可促进人混合淋巴细胞 产生 IL22。但 Kiremidjian2Schumacher 等[5 ] 以C57BL/ 6J 小鼠为研究对象 ,从摄食 2. 0 mg/ kg 硒 8周的小鼠分离得到的淋巴细胞和巨噬细胞产生 IL22 和 IL21 的量与对照组无显著差异。Kiremidian2Schumacher 等认为硒可能是IL22R 的表达所需的元素 ,硒通过调节淋巴细胞表面 IL22R 的表达数量来发挥作用 ,而 Roy 等[ 22 ]认为硒主要通过淋巴细胞受到致丝裂原或抗原刺激后 8~24 h 结合和调节特异的细胞质蛋白及核苷酸而发挥作用?;褂醒д呷衔拿庖呋撇皇峭ü馨拖赴钥乖?(或丝裂原) 刺激的反应生成免疫活性细胞 ,也不是通过调节IL22 的产量 ,而是通过其他未知的途径。
也有少量关于细胞因子对硒代谢影响的研究资料。用 IL21β、TNF2α、IFN2γ处理 Hep G2 肝细胞 , 对硒蛋白 P 的表达无影响[23 ] 。但是转化生长因子β(100 pmol/ L 处理 48 h) 导致硒蛋白P 的 mRNA 表达下降 21 % ;同时还下调 GSH2Px1 和过氧化氢酶的 mRNA 表达 ,并降低酶活性[23 ] 。
3 硒对非特异性免疫功能的影响
皮肤是机体抵抗外界刺激的最大屏障 ,长期暴露于多种应激状态下 ,包括体表寄生虫及紫外线照 射引起的氧化应激和细胞损伤。适量蛋氨酸硒和亚硒酸钠均能?;そ侵氏赴?、黑色素细胞和成纤维细胞由紫外线诱导的细胞死亡和凋亡。其?;ぷ饔没戆?,抑制 DNA 氧化损伤、脂质过氧化和凋亡 ,抑制炎症介质和免疫抑制性细胞因子释放和调节P53 活性。体内试验表明 ,紫外线照射后硒缺乏导致多核巨细胞的浸润减少 ,从而降低皮肤的免疫功能[ 17 ] 。J aspers 等[24 ]建立了硒缺乏对支气管上皮细胞形态学影响的体外模型 ,结果显示 ,硒缺乏对支气管上皮细胞纤毛的产生无明显影响 ,但却导致黏液分泌亢进 , 并认为硒缺乏时支气管上皮细胞内GSH2Px 酶数量下降、活性降低导致的氧化应激是引起黏液分泌亢进的基础 ,而黏液分泌增多可导致细胞对肺部感染病毒的易感性增强。
硒对吞噬细胞趋化、吞噬和杀灭三大过程均有不同程度的影响。缺硒大鼠、山羊和奶牛的中性粒细胞游走能力严重下降。GSH2Px 和硫氧还蛋白还原酶这两种含硒酶通过影响类花生酸代谢而调节炎症反应和趋化活性成分[16 ] ??墒谷蔽∈蠖嘈魏税紫赴耐淌赡芰Φ玫礁纳?;补硒还可以使人的巨噬细胞吞噬活性增强 ,杀菌能力增强 ;在巨噬细胞的激活因子(MAF)激活巨噬细胞时 ,硒具有增强 MAF的作用 ,还可增强巨噬细胞对 MAF 的反应性。
研究显示 ,硒缺乏时机体对自由基损伤的?;ぷ饔媒档?;虽然不影响中性粒细胞的数量 ,但却导致其杀菌能力发生障碍[ 10 ,25 ] 。来源于硒缺乏小鼠、大鼠和牛的中性粒细胞能够吞噬病原菌 ,但杀伤病原的能力却较足硒动物低[26 ] 。引起这一现象的原因与中性粒细胞胞质内的谷胱甘肽过氧化物酶活性下降 ,不能?;は赴陨砻馐芎粑醣⒐讨胁淖杂苫乃鹕擞泄亍5图亮康奈砑踊崽岣呶狈π∈?GSH2Px 的活性 ,但过高剂量的硒添加又会降低 GSH2Px 的活性[27 ] 。在体内因素中还应考虑中性粒细胞功能可被其他因素调节 ,包括硒缺乏时受到损伤的甲状腺激素代谢 ,甲状腺功能减退会降低中性粒细胞对外来微生物的应答能力。
4 硒对细胞免疫的影响
4. 1 硒对淋巴细胞增殖能力的影响
硒缺乏时 ,动物的淋巴细胞增殖能力下降 ,补硒能增强外周血和脾淋巴细胞对丝裂原刺激的转化能力 ,但过高剂量的硒又会降低淋巴细胞增殖能力。硒和维生素 E 缺乏时 ,人、猪、犬、鼠和牛等的淋巴细胞对 PHA 和 ConA 刺激的增殖反应能力降低[28231 ] 。小鼠硒缺乏时脾细胞受刀豆素 A 诱导的T 细胞增殖能力较弱 ,但在添加亚硒酸钠后 ,其增殖能力有显著提升[32 ] 。添加硒或维生素 E 也可使猪、牛和羊淋巴细胞对植物血凝素刺激的增殖反应增强[33234 ] 。人、鼠和羊的研究显示 ,体外加入亚硒酸钠超过一定浓度水平后 ,均能抑制外周血淋巴细胞的转化增殖能力[35236 ] 。
4. 2 硒对淋巴细胞亚群的影响
动物体内功能已明确的淋巴细胞包括 T 淋巴细胞、B 淋巴细胞和自然杀伤细胞。B 淋巴细胞参与体液免疫。根据 CD4 和 CD8 蛋白的表达情况 , T淋巴细胞又分为两大亚类[37 ] 。在已有的研究资料中 ,针对硒缺乏和高硒对 T细胞的影响更大 ,还是对 B 细胞的影响更大的问题 ,不同的学者有不同看法。Daniels[ 38 ] 认为抗氧化微营养中的硒缺乏对 T 细胞的影响大于对 B 细胞 的影响 ,是因为 T 细胞膜的流动性大于 B 细胞膜 , T细胞膜的脂质比 B 细胞脂质更易过氧化。有研究发现 ,胸腺组织中含有含硒酶 ———2 型碘化甲腺氨酸脱碘酶 ,硒缺乏时 ,此酶功能降低,可能影响胸腺细胞的发育和功能[39 ] ,由此可能影响 T 淋巴细胞功能。而 Vega 等[40 ]却观察到低硒摄入对 B 细胞的毒性作用大于对 T 细胞的毒性作用 ,小鼠摄入硒缺乏日粮或高剂量蛋氨酸硒时 ,小鼠脾的 CD4 + T 细胞 数量增多 ,同时低硒摄入致小鼠CD8 + T 细胞数量增多 ,而 B 淋巴细胞亚群 CD19 + 细胞百分率在低硒和高硒摄入时均有明显减少。笔者认为脾 T 细胞亚群比例增多并非绝对数量增多 ,而是因为硒的 B细胞毒性作用导致 B 淋巴细胞减少 ,导致 T 细胞相对增多。Pollock 等[41 ]研究了维生素 E 和硒在体外对牛的细胞免疫的影响 ,发现日粮中维生素 E 与硒水平可改变循环淋巴细胞亚群比例 ,当硒和维生素E 缺乏时 ,CD4 + 细胞增加。阎丽等[42 ] 的研究结果显示 ,对健康大鼠补硒 ,会导致 CD4 + 、CD8 + 细胞比例均有所下降。
4. 3 硒增强淋巴细胞的细胞毒功能
以 200μg/ d 剂量水平持续补硒 8 周的人 ,细胞毒性 T 淋巴细胞的活性上调 118 % ,自然杀伤细胞的活性上调 82 % ,同时抑制性 T 淋巴细胞活性降低[ 43 ] 。伴随着 IL22R 的上调表达 ,人的自然杀伤细胞和淋巴因子活化型杀伤细胞的溶细胞能力得到增强[ 44 ] 。在大鼠饮水中以亚硒酸盐为硒源分别给予0. 2、2. 0 和 5. 0 mg/ kg 硒 ,结果在 0. 2 和 2. 0 mg/ kg 组自然杀伤细胞活性增强 ,但 5. 0 mg/ kg 硒组 N K细胞活性与未补硒组相似。前列腺素 E2 产生在所有补硒组均被抑制。缺硒小鼠的 T 淋巴细胞和 N K细胞在体外杀伤癌细胞的能力下降 ,补硒后其功能恢复。Kiremidjian 等[44 ] 认为 ,硒对细胞毒性 T 淋巴细胞(CTL) 的作用发生于 CTL 的产生过程 ,而不是发生于 CTL 对靶细胞的作用过程。
当硒浓度过高时 ,又会降低淋巴细胞的毒性作用。对人的体外研究显示 ,当在培养物中加入高达 0. 8μg/ mL 亚硒酸盐时 ,N K 细胞和淋巴因子活化型杀伤细胞的活性降低 ;同时当硒浓度在 0. 5~1. 0μg/ mL时 , T 淋巴细胞的增殖能力也降低[45 ] 。
5 硒对体液免疫的影响
5. 1 硒对免疫球蛋白及其亚类的影响
硒摄入不足会导致机体免疫球蛋白合成不足 ,免疫球蛋白亚类中的 Ig G、IgA 和 IgM 含量也有不同程度的下降 ,适量补硒则能提高免疫球蛋白亚类的含量。Bires 等[46 ] 对成年母羊补充瘤胃内硒丸0152 g ,4~7 个月后 ,血清免疫球蛋白浓度达到最高 ,并显著高于未补硒的母羊。硒缺乏时 ,大鼠和小鼠 Ig G、IgA 和 IgM 的效价下降[47 ] 。新生犊牛天生缺硒 ,适量补硒可提高新生犊牛血浆 IgA 水平[48 ] 。体外试验中 ,适量加硒能促进犊牛淋巴细胞合成IgM 的能力[ 49 ] 。小鼠摄入高达 9. 5 mg/ kg 日粮硒 ,在腹腔注射绵羊红细胞悬液 14 d 后 ,机体产生 Ig G和 IgM 的能力仍较不加硒组有大幅提升。Knight等[50 ]对成年雪特龙马补硒则提高了对绵羊红细胞应答的血清 Ig G含量。
5. 2 硒对免疫接种后动物体液免疫活性的影响
大量研究资料表明 ,在疫苗接种前或接种的同时 ,用日粮中补充、服用硒丸或肌肉注射硒剂等方法补硒 ,可提高牛、羊、猪及家禽等多种动物的免疫接种效果 ,表现为血清中某种免疫球蛋白亚类的浓度升高或疫苗的血清抗体效价高于未补硒组。对牛羊的研究显示 ,缺硒牛羊补硒 ,可提高对牛传染性支气管炎病毒、副流感病毒、布氏杆菌、钩端螺旋体菌、巴氏溶血菌和梭状芽胞杆菌类毒素等免疫的抗体效价[51 ] 。Droke 等[52 ] 用含硒 0. 9 mg/ kg 的日粮饲喂断仍仔猪 ,发现仔猪对溶菌酶免疫的血清抗体效价明显高于饲喂含硒 0. 3 mg/ kg 的日粮组。对家禽的研究显示 ,在日粮中联合添加硒和维生素 E 可提高对新城疫病毒的抗体效价 ,并可同时促进鸡的体 重增长[17 ] 。家禽摄入富硒日粮可有效提高对沙门氏菌和黄曲霉毒素接种的抗体效价[ 53 ] 。
6 硒对红细胞免疫的影响
近几年 ,微量元素对动物红细胞免疫功能的影响开始受到关注[54256 ] 。硒缺乏是许多国家和地区的地方性流行病 ,严重危害人畜健康。张培毅等[ 57258 ]的研究显示 ,硒缺乏所致的克山病和大骨节病患者以及低硒非病区居民的红细胞 C3 bR 花环率降低 ,IC花环率无明显改变。有学者报道 ,适量补硒可促进红细胞免疫黏附功能 ,促进抗体有效产生[59 ] ,而日粮硒过量则导致家禽红细胞免疫黏附功能下降[55 ] 。
7 硒与抗病力
硒增强动物对病原体感染的抵抗力与硒增强动物的免疫功能密切相关。对实验动物和畜禽的研究表明 ,硒能够增强机体对寄生虫感染的抵抗能力。Colnago 等[ 53 ]的试验结果显示 ,喂给富硒日粮的雏鸡对艾美球虫攻击的抵抗力增强 ,且感染球虫后的白细胞总数特别是异嗜性白细胞总数增加。有资料报道 ,补给高硒的小鼠对疟原虫的抵抗力增强 ,存活率明显高于对照组。用睡病虫注射感染啮齿动物的同时 ,以亚硒酸钠为硒源在饮水中添加 0、2、4、8 和 16 mg/ kg硒。攻毒后第 4 d ,未加硒组的小鼠全部死亡 ,但 4 和 8 mg/ kg 处理组的小鼠有 60 %存活。 16 mg/ kg 组的小鼠存活率又较 4 和 8 mg/ kg 组低 ,提示硒在最适剂量才能有效发挥其?;ばв60 ] 。
硒缺乏时免疫功能的改变导致机体对肿瘤的易感性增加 ,对一些急性炎症过程和病毒感染性疾病的易感性也增加 ,导致病情加重[ 8 ] 。Beck 等[ 61 ]以无沙门氏菌、无腹泻的猪为研究对象 ,研究了硒对密螺旋体感染的影响 ,结果表明 ,补硒组猪增重明显 ,结肠损伤轻微 ,50 %的猪结肠中未分离出猪密螺旋体菌。龚伟等[2 ]综述了硒与奶牛乳房炎和子宫内膜炎的相关性。国内外研究资料表明 ,给奶牛补硒能有效改善机体的硒营养状况 ,降低乳中体细胞计数 ,降低隐性乳房炎和临床乳房炎的发病率 ,同时还可降低子宫内膜炎的发病率。对缺硒犊牛适量补充硒和维生素 E 能显著提高增重 ,并降低肺炎的发病率、缩短病程。对人的研究表明 ,硒缺乏时 ,病毒变异率增加 ,用硒剂治疗可减少由细胞因子诱导的艾滋病病毒的复制[ 61 ] 。硒使各种动物达到最佳免疫能力的剂量范围至今尚未明确。因此 ,研究硒与动物免疫功能的关系、确定硒化合物的适宜治疗剂量是动物医学领域应探索的内容之一。
参考文献( References)
[1 ] 吴跃明. 硒对动物免疫机能的影响[J ]. 中国畜牧杂志 ,1996 ,32(5) :58259.
WUYue2ming. Effect of selenium on animal immune function [J ].
Chinese J ournal of A nimal S cience ,1996 ,32 (5) : 58259. (in Chinese)
[2 ] 龚伟 ,王哲. 硒对免疫功能影响的研究进展[J ]. 动物医学进展 ,
1998 ,19 (4) :16218.

GON G Wei ,WAN G Zhe. Advance in effects of selenium on im2
mune function [J ]. Progress in Veterinary Medicine ,1998 ,19
(4) :16218. (in Chinese)
[3 ] 曹来福. 硒对免疫功能的影响[J ]. 国外医学 :卫生学分册 ,
1987 ,14 (3) :1322135.
CAO
Lai2fu. Effect of selenium on immune function [J ]. Fo2
rei gn
Medical S ciences : S ection of Hy giene ,1987 ,14 (3) :1322
135. (in Chinese)
[4 ] D YL EWSKI M L ,MASTRO A M ,PICCIANO M F. Maternal
selenium
nutrition and neonatal immune system development

[J ]. Biol
Neonate ,2002 ,82 (2) :1222127.
[5 ] KIREMIDJ IAN2SCHUMACHE R ,RO Y L ,WISHE M , et al .
Regulation of cellular immune responses
by selenium[J ]. B iol
T race Element Res ,1992 ,33 (1) :23235.
[6 ] KIREMIDJ IAN L , RO Y M , WISHE
I , et al . Selenium and
immune cell functions. Ⅰ. Effect on
lymphocyte proliferation
and production of interleukin 1 and interleukin 2[J ].
Ex p Biol
Med ,1990 ,193 (3) :1362142.

[ 7 ] HAWKES W C ,
KELL EY D S , TA YLOR P C. The
effects of
dietary selenium
on
t he immune system in healt hy
men [J ].
B iol Trace Element
Res ,2001 ,81 (3) :1892213.
[ 8 ] SPALL HOLZ J E ,BO YLAN L M ,LARSEN H S. Advances in
understanding selenium’
s role in t he immune system[J ]. A nn
N Y A cad S ci ,1990 ,587 (1) :1232139.
